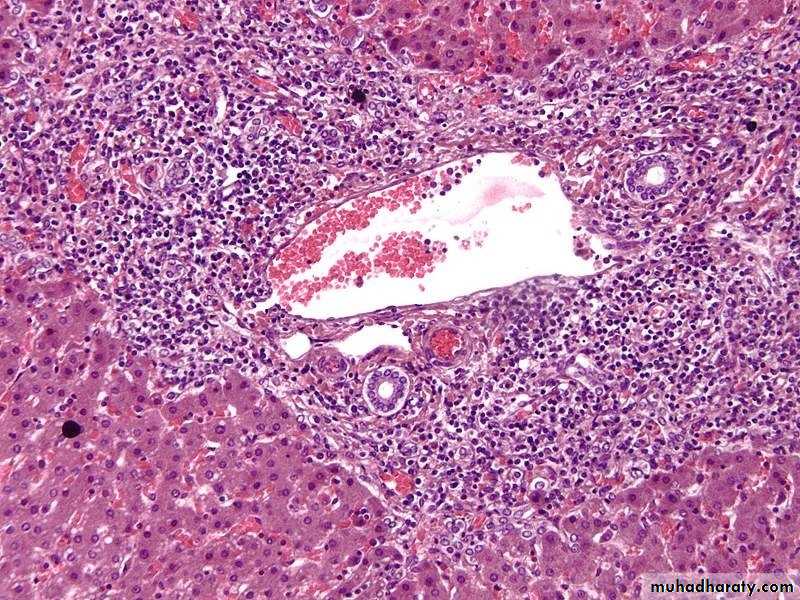

Hepatobiliary and pancreatic disorders
ANATOMY This is the external surface of a normal liver. The color is brown and the surface is smooth. A normal liver is about 1200 to 1600 grams.
HISTOLOGY
• Hexagonal plates
• Portal Triads• Bile duct branch
• Arteriole
• Venuole
• Blood flows from periphery to Central vein
• Sinusoids
The center of the lobule is the central vein. At the periphery of the lobule are portal triads. Functionally, the liver can be divided into three zones, based upon oxygen supply. Zone 1 encircles the portal tracts where the oxygenated blood from hepatic arteries enters. Zone 3 is located around central veins, where oxygenation is poor. Zone 2 is located in between.
Patterns of hepatic injury
Following hepatic injury, the liver has a limited set of responses:Necrosis
Inflammation
Regeneration
Fibrosis.
LABORATORY EVALUATION OF LIVER DISEASE Hepatocyte integrity, enzymes -(AST, ALT)
Hepatocyte function -(serum albumin, prothrombin time)Biliary excretory function -substances secreted in bile .(serum bilirubin)
-plasma membrane enzymes (from damage to bile canaliculi) .(serum alkaline phosphatase)
FUNCTIONS
The liver performs multifold functions:• Synthesis of several major plasma proteins.
• Metabolism of proteins, carbohydrates and lipids.
• Storage of vitamins (A, D and B12) and iron.
• Detoxification of toxic substances such as alcohol and drugs.
• Manufacture and excretion of bile
BILIRUBIN METABOLISM AND BILEFORMATION
Bilirubin Production:
Source of Bilirubin
Major (85%) is derived from the catabolism of hemoglobin during the breakdown of senescent red cells.Minor (15–20%) is derived from the degradation of heme produced from other sources ( premature destruction of hemoglobin in developing red cell precursors in the bone marrow).
Bile Formation
Hemoglobin breakdownConversion in liver to water soluble form Bilirubin
Excretion in bileSome is reabsorbed
Jaundice and Cholestasis
Definition: yellowish pigmentation of skin, mucous membranes and sclera due to increased levels of bilirubin in the blood. .
Normal serum bilirubin level: 0.3 to 1.2 mg/dL.
Jaundice: > 2.0 to 2.5 mg/dL.
Indirect hyperbilirubinemia is called when unconjugated bilirubin is 85% or more of the total bilirubin.
insoluble in water complexed to serum albumin, it can not be secreted in urine.
Direct hyperbilirubinemia corresponds to conjugated bilirubin more than 15% of total.
Conjugated bilirubin is water soluble & loosely bound to albumin. It's excess can be excreted in urine.• Classification of Jaundice
1. Based on the type of bilibobin:Predominantly unconjugated
Predominantly conjugated.
2. Based on the underlying cause:
Hemolytic jaundiceHepatocellular jaundice
Obstructive jaundice.
Predominantly Unconjugated Hyperbilirubinemia
1- Excess Production of BilirubinHemolytic anemias
Ineffective erythropoiesis
Internal hemorrhage (e.g.hematomas)
2- Reduced Hepatic Uptake
Drugs
Diffuse hepatocellular disease (e.g., viral or drug-induced hepatitis, cirrhosis)
3- Impaired Bilirubin Conjugation
Physiologic jaundice of the newborn
Predominantly Conjugated Hyperbilirubinemia
4- Decreased Hepatocellular Excretion
Drug-induced canalicular membrane dysfunction (e.g., oral contraceptives)
Hepatocellular damage or toxicity (e.g., viral or drug-induced hepatitis)
5- Impaired Intra- or Extrahepatic Bile Flow
Inflammatory destruction of intrahepatic bile ducts (e.g., primary biliary cirrhosis, primary sclerosing cholangitis ) gall stones, carcinoma of the pancreas
• Causes of Jaundice
CHOLESTASIS
Definition : is the impairment of bile flow resulting in the retention of bilirubin, bile acids, and cholesterol.Clinical features : jaundice, pruritis, skin xanthomas, malabsorption syndrome.
Results from: - Primary hepatocellular dysfunction (e.g. neonatal cholestasis, drug cholestasis, sepsis) .
- Bile duct injuries, mechanical (e.g., obstruction of large ducts by stones or tumor) or inflammatory (such as autoimmune diseases).
Characteristic laboratory finding: elevated serum alkaline phosphatase
Morphology :
1.Accumulation of bile pigment within hepatic parenchyma :2.Distention of bile ducts
3. bile lakes with cellular debris &pigment .
4. Portal tract edema.
5. Portal fibrosis on long standing obstruction leading to biliary cirrhosis
Liver, intracellular cholestasis
Cholestasis: Prominent bile plugs are present in dilated canaliculi .CIRRHOSIS
Definition : It is the end stage of chronic liver disease defined by three characteristics:1. Disruption of the architecture of the entire liver
2. Bridging fibrous septae : bands of fibrosis that link portal tracts with one another and portal tracts with centrilobular veins.
3. Parenchymal nodules containing regenerating hepatocytes encircled by fibrosis
Types :
micronodular ( if nodule is <3mm)
macronodular (>3 mm)
mixed.
Causes of cirrhosis
• Alcoholic liver disease
• Viral hepatitis
• Non-alcoholic steatohepatitis (NASH)
• Autoimmune liver disease (autoimmune hepatitis and primary biliary cirrhosis)
•primary Hemochromatosis
• Wilson disease
• a-1-antitrypsin deficiency
•Cryptogenic/idiopathic
Pathogenesis
Four important processes are involved:Death of liver cells with loss of architecture.
Regenerating nodules: The surviving hepatocytes regenerate and proliferate to form regenerating nodules.
Fibrosis : It is mainly due to the activation of hepatic stellate cells, which are transformed into highly fibrogenic cells called myofibroblasts.
Vascular reorganization: The parenchymal damage and fibrosis disrupt the vascular architecture of the liver.
Clinical features
-asymptomatic-non-specific (anorexia, weight loss , weakness)
-hepatic failure
Complications of cirrhosis
Death is due to :1. Progressive liver failure
2. Portal hypertension related complications
3. The development of hepatocellular carcinoma.
• Histopathological Features of cirrhosis:
Grossly• The liver may be normal in size, enlarged, or shrunken.
• The cut surface has a firm texture and shows diffuse nodularity.
Microscopically
The regenerative nodules of hepatocytes are surrounded by fibrous connective tissue that bridges between portal tracts
CIRRHOSIS, TRICHROME STAIN
INFLAMMATORY & INFECTIOUS DISORDERS
INFLAMMATORY & INFECTIOUS DISORDERSVery common condition , include:
• Infection
• Viruses
• Hepatic specific
• EBV
• CMV
• Bacteria
• Cholangitis
• Abscesses
• Parasites
• Autoimmune
• Toxins and drugs
Viral Hepatitis
Definition: viral infection of hepatocytes that produces necrosis and inflammation of the liver.
It is a common cause of hepatitis.
Generally taken to mean hepatic specific viruses.
Hepatitis A
RNA picovirusTransmission—faecal-oral route
Time course— incubation period of 2-6 weeks .
virus is shed in stool for 2-3 wks before & 1 wk after onset of jaundice can also be detected in serum & saliva.
Prognosis— self-limited disease
Full recovery with restoration of normal liver function tests.
No chronic hepatitis
No carrier state
The fatality rate associated with HAV is only about 0.1-0.3%.
A vaccine is available for long-term immunity.Hepatitis B
DNA virus of the Hepadna group. It can integrate into host DNA.Incubation period 4-26 wks.
Transmission :
• • blood-borne—blood transfusions, IV drug abusers,
• tattooing, acupuncture
• • sexual—sexual intercourse
• • vertical—transmission from mother to child; either
• perinatally (transplacental) or postnatally (breast
• milk).
The viral genome encodes:
Surface glycoprotein (HBs Ag).Anucleocapsid core protein (HBc Ag ) .
A DNA polymerase which exhibit reverse transcriptase activity .
A protein (HBX) act as transcriptional transactivator ,is necessary for viral replication ,play a role in hepatocellular carcinoma.
Potential outcomes of hepatitis B infection in adults
Potential outcomes of hepatitis B infection in adults -acute hepatitis with recovery -nonprogressive chronic hepatitis -progressive chronic disease>cirrhosis -fulminant hepatitis -asymptomatic carrier state (presence of HBs Ag in serum for 6 months or longer) -hepatocellular carcinoma
Hepatitis C Virus
This RNA flavivirus• Incubation period 2-26 weeks
• Transmission
—predominantly blood-borne spread among intravenous drug, although sexual and vertical transmissions do occur.
The potential outcomes of hepatitis C infection in adults
The potential outcomes of hepatitis C infection in adults -acute hepatitis. -chronic hepatitis. characteristic clinical feature is episodic elevations in serum aminotransferases -cirrhosis. in 20%-30% of patients with chronic infection after 5-20y of acute infection
Pathological features of viral hepatitis
1- Acute viral hepatitis2- Chronic viral hepatitis
Acute viral hepatitis
1. Inflammation:– Lobular inflammation: Inflammation involving liver parenchyma throughout the lobule mainly consists of lymphocytes and macrophages.
– Interface hepatitis .
2. Hepatocyte injury:
– Ballooning degeneration: swelling of hepatocytes, empty and pale stained cytoplasm .– Hepatocyte necrosis:
i. Dropout necrosis: aggregates of macrophage around necrotic hepatocyte.ii. Councilman body: Apoptotic hepatocytes shrink become intensely eosinophilic and have with a densely staining pyknotic or fragmented nuclei .
iii. Bridging necrosis : band/zone of necrosis may extend from portal tract to portal tract, central vein to central vein, or portal-to-central regions of adjacent lobules.
3. Lobular disarray: disruption of the normal orderly architecture of the liver
cell plates.
Chronic viral hepatitis
1- Inflammation:
i. Portal inflammation: In mid hepatitis, inflammation is limited to portal tracts and predominantly consists of lymphocytes, macrophages, and occasional plasma cells.
ii. Interface hepatitis (periportal necrosis): It is spillover of inflammatory cells from portal tract into the adjacent periportal hepatocytes.
iii. Parenchymal inflammation and necrosis: It is variable in severity but usually spotty. Mononuclear inflammatory cells surround the damaged hepatocytes. Bridging necrosis between portal tracts and portal tracts-to-terminal hepatic veins may be seen.
2. Fibrosis: It is the hallmark of chronic liver damage due to continued inflammation and associated necrosis.
a. portal tracts.
• Periportal fibrosis
• bridging fibrosis between adjacent fibrotic portal tracts (i.e. portal to portal) or portal-central.
Acute viral hepatitis, Lobular inflammation
Ballooning degeneration
Chronic viral hepatitis, Portal Inflammation
Chronic viral hepatitisChronic HBV hepatitis, ground-glass hepatocytes
ALCOHOLIC LIVER DISEASE
ALCOHOLIC LIVER DISEASEExcessive ethanol consumption is a common cause of chronic liver disease in Western countries and accounts for up to 50% of deaths due to cirrhosis.
Chronic heavy drinkers are predisposed to 3 distinctive forms of alcoholic liver disease; these may overlap.
1. Hepatic steatosis (almost all heavy drinkers)
2. Alcoholic steato hepatitis (30%)
3. Cirrhosis (15%)
Steatosis
SteatohepatitisCirrhosis
ALCOHOLIC LIVER DISEASE
ALCOHOLIC LIVER DISEASE
Alcoholic cirrhosis
Alcoholic hepatitis
Hepatic steatosis
• Irreversible form of
alcoholic liver disease
• Initially, liver is
enlarged and laterthere is presence of
micronodules .
• Later, the whole liver
has tough, pale scartissue (Laennec
Cirrhosis).
• Grossly : liver is mottled red & yellow-green (bile stained) may increase in size.
•hepatocyte swelling
and necrosis (ballooningdegeneration)
• Neutrophilic infilitration in lobule
• Perivenular and periportal
fibrosis• Some hepatocytes show eosinophilic, cytokeratin filaments called
‘Mallory Hyaline bodies’.• Grossly : liver is large (up to 4 or even 6 kg), soft, yellow, and greasy
• small (microvesicular) or
large (macrovesicular)lipid droplets inside the
hepatocytes
• Initial centrilobular
involvement followed byentire lobule involved
• Reversible if there is
abstinence from alcohol.Hepatic Steatosis (Fatty Liver)
Alcoholic Hepatitis
Liver cell ballooningdegeneration
Neutrophils
Mallory bodiesAlcoholic Cirrhosis
About 15-20% of alcoholicsMicronodular pattern.
METABOLIC LIVER DISEASE
METABOLIC LIVER DISEASE1. Nonalcoholic fatty liver disease
2. Hemochromatosis3. Wilson disease
4. α1-antitrypsin deficiency.
Nonalcoholic Fatty Liver Disease (NAFLD)
May present as :Steatosis (fatty liver)
Nonalcoholic steatohepatitis (NASH) similar to alcoholic hepatitis.
Cirrhosis.
Pathogenesis: genetics & environment factors
“two-hit” model .hepatic fat accumulation .hepatic oxidative stress
1. Insulin resistance including Type 2 diabetes, is the most common associated condition . Insulin resistance results in the accumulation of triglycerides in hepatocytes.
2. Obesity
3. Dyslipidemia (hypertriglyceridemia, low HDLP cholesterol, high LDLP cholesterol).
The presence of type 2 diabetes and obesity are the best predictors of severe fibrosis and disease progression.
Clinical features :
Most persons with steatosis are asymptomatic; NASH may also be asymptomatic, or present with symptoms of chronic liver disease.
Steatosis (fatty liver)
Non-alcoholic steatohepatitis. Moderate macrovesicular fatty change is seen with a moderate predominantly neutrophilic infiltrate.
Non-alcoholic fatty liver disease, cirrhotic stage. regenerative nodules are small and rather well-circumscribed (“micronodular”). Moderate fatty change is present.
HEMOCHROMATOSISExcessive accumulation of body iron, mostly in liver & pancreas Types -primary -secondary (hemosiderosis)
primary (hereditary) hemochromatosis
• Autosomal recessive, due to excessive intestinal absorption of iron
• Mainly at 5th decade of life
• Males predominate by 5:1 to 7:1
• Fully developed cases show trade of :
1. Cirrhosis (all patients)
2. Diabetes mellitus (75%)
3. Skin pigmentation (75%).
• Pathogenesis: Excessive iron is toxic to tissues through: -lipid peroxidation via free radicals. -stimulation of collagen via activation of stellate cells -interaction of reactive oxygen species & iron with DNA lethal cell injury or hepatocellular carcinoma
Microscopic features
The golden-yellow hemosiderin granules accumulate in the cytoplasm of periportal hepatocytes; these stain blue with the Prussian blue stain.Iron is a direct hepatotoxic, and inflammation is characteristically absent.
Hemochromatosis, golden-yellow hemosiderin granules accumulate in the cytoplasm of hepatocytes
Hemochromatosis, Prussian blue stain
WILSON DISEASE
Autosomal-recessive disease due to deficiency of ATP7B enzyme, results in deposition of cupper in various tissues: - liver, (steatohepatitis, necrosis, cirrhosis) - brain, (damage to basal ganglia) - eye, (Kayser-Fleischer ring)Copper physiology:
-Absorption from GIT (2-5mg/day) to the liver.-In hepatocytes some cupper molecules bind to ceruloplasmin (copper- binding protein) by enzyme ATP7B ,while the excess of cupper excreted to the bile.
-Resecretion of ceruloplasmin in plasma.
.In wilson dis.
Copper absorption & transport to liver is normalFailure of ceruloplasmin formation & biliary excretion of Copper is ⇓ ↠ Copper accumulation in liver ↠ toxic free radicals injury.
With time ,Copper is deposited in other organs (brain & cornea) with ↑ urinary excretion of copper.
Morphology:
acute hepatitis
chronic hepatitis
cirrhosis
massive liver necrosis
copper can be demonstrated on liver biopsy by special stain (Rhodanin stain ).
Kayser-Fleischer Rings
Rhodanin stainα1-Antitrypsin Deficiency
Autosomal recessive disease.α1- antitrypsin enzyme is synthesized in hepatocytes, it is a major protease inhibitor to neutrophil elastase secreted at inflammatory sites.
Pathogenesis
-Mutation cause misfolded protein which accumulate in the endoplasmic reticulum.- Accumulation of α1AT in endoplasmic reticulum leads to: .mitochondrial dysfunction .inflammation & hepatocyte damage
Morphology :
The hepatic involvement ranges from neonatal hepatitis with fibrosis to childhood cirrhosis to chronic hepatitis & cirrhosis appear later in life.Liver cells contain round to oval cytoplasmic globular inclusions which are acidophilic.